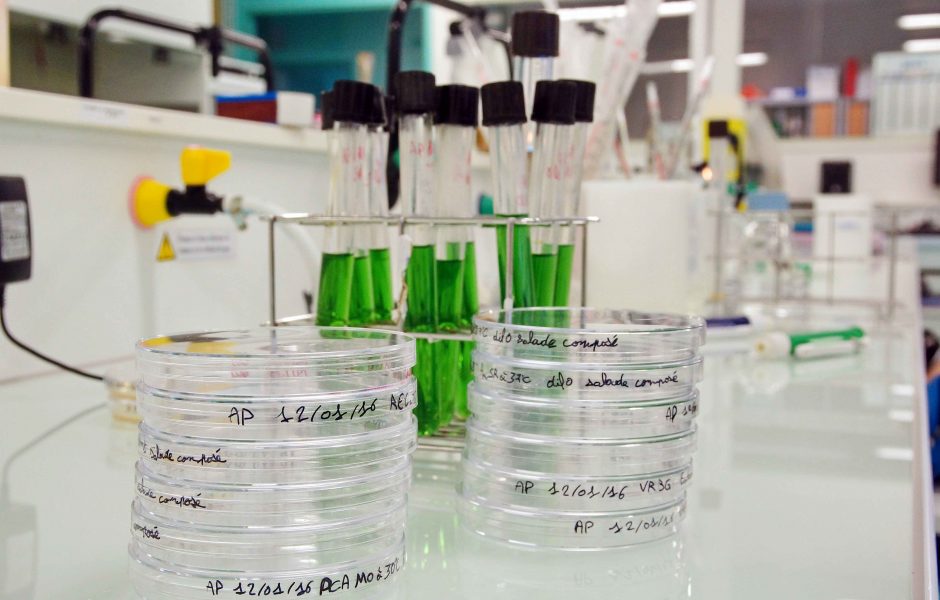
&copy;

Les ENIL de Franche-Comté ouvrent leurs portes !
Publié le 03/03/2018 - 07:30
Mis à jour le 03/03/2018 - 07:30
Durant toute une journe?e, de 9h a? 17h, les visiteurs pourront de?couvrir les installations et les ateliers des e?coles et constater leur modernite?. Au-dela? de la seule de?couverte des e?quipements des e?tablissements, les visiteurs, au contact des enseignants et des apprenants, auront l’occasion sur les deux campus de bien cerner l’ensemble des formations propose?es ainsi que l’esprit et la philosophie propre aux deux e?coles.
Si cet e?ve?nement est ouvert a? tous, il s’adresse en priorite? aux colle?giens, lyce?ens et aux e?tudiants post bac qui souhaitent s’informer sur leur future orientation, ainsi qu’aux adultes en reconversion professionnelle.
Au contact des enseignants, des formateurs et des jeunes actuellement en formation, ils auront la possibilite? de se faire une ide?e pre?cise des formations propose?es, des de?bouche?s et carrie?res, des me?tiers ainsi que de l’ambiance et de l’esprit de l’e?cole.
Ils disposeront alors de tous les e?le?ments d’informations ne?cessaires pour arre?ter un choix et e?ventuellement rejoindre l'une des ENIL de?s la rentre?e prochaine.
L’entre?e est libre et gratuite pour tous. Les visiteurs pourront aussi donner a? leur visite une touche gourmande et une touche curiosite? en passant par les diffe?rents ateliers de de?gustation et d'animations, les boutiques des e?coles ou? de nombreux produits e?labore?s avec les apprenants (Comte?, Mamirolle, Polinois, Morbier, Mamirollais, St Savin, Pre?paillou, Grimont, Cancoillote, Faisselle, Yaourts, Bie?res...) sont propose?s a? la vente.
Infos +
- L’ENIL de Besançon-Mamirolle et l'ENILBIO de Poligny sont des e?coles publiques qui fe?tent en 2018 et en 2019 leurs 130 ans d’expe?rience. Elles forment chaque anne?e pre?s de 600 personnes dans des secteurs dynamiques et porteurs d'emplois : la transformation laitie?re, l’agroalimentaire, l’eau, le laboratoire, la brasserie, les biotechnologies, la qualite? et l’innovation produits.
- Les formations propose?es de?bouchent sur des diplo?mes de niveau : CAP, bac pro, BTS et licences pro.
- Le taux d’insertion des e?le?ves (insertion professionnelle a? 6 mois et poursuite des e?tudes) s’e?leve a? plus de 94 %.
- Plus d’informations sur : www.enil.fr et sur Facebook.





